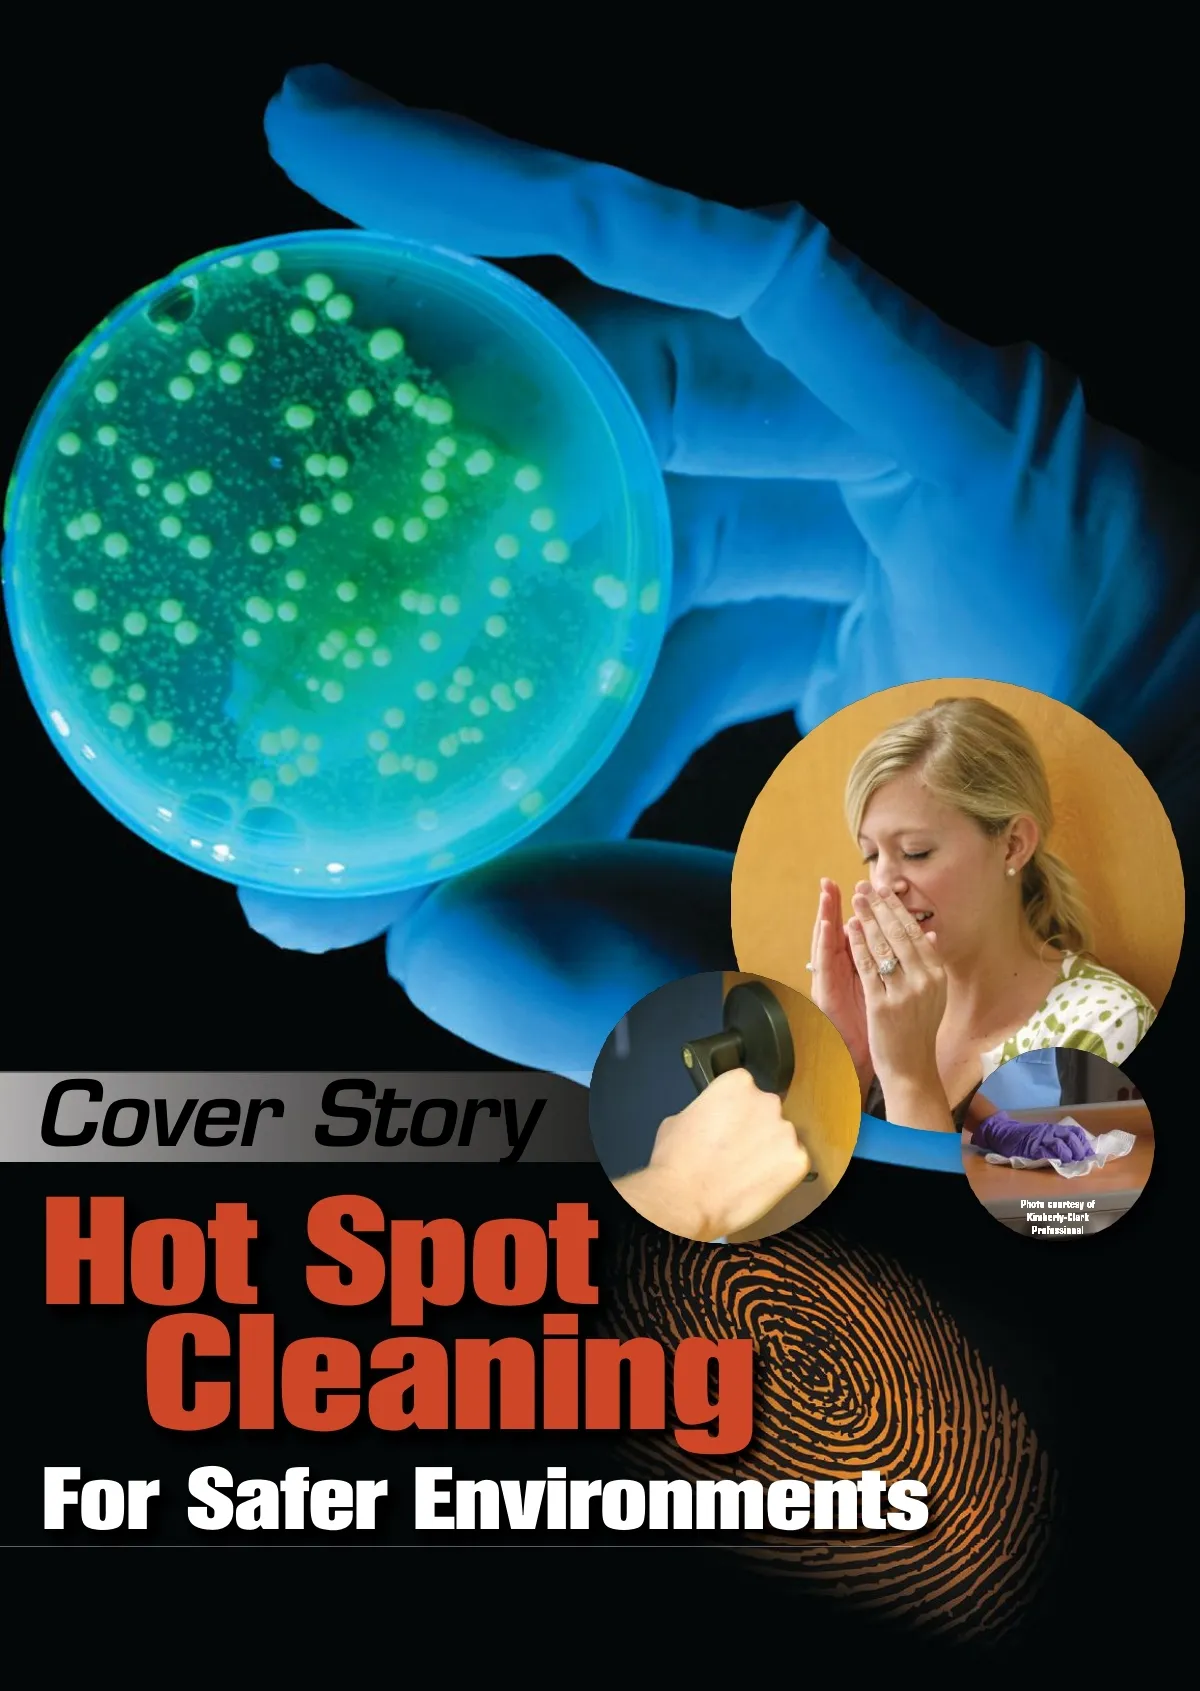

Cover Story Hot Spot Photo courtesy of Kimberly-Clark Professional Cleaning For Safer Environments
CMM – Archives Sept 2009: 10


Cover Story Hot Spot Photo courtesy of Kimberly-Clark Professional Cleaning For Safer Environments